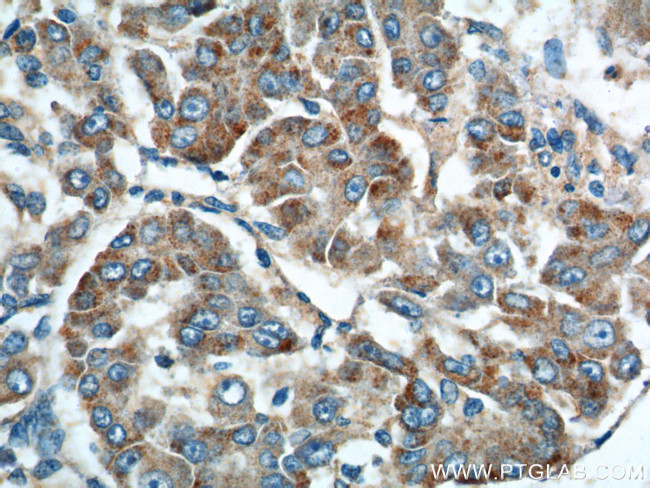
Rab23 Antibody in Immunohistochemistry (Paraffin) (IHC (P))
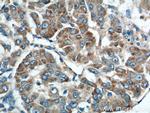
Rab23 Antibody in Immunohistochemistry (Paraffin) (IHC (P))

Search
Proteintech
Rab23 Polyclonal Antibody
{{$productOrderCtrl.translations['antibody.pdp.commerceCard.promotion.promotions']}}
{{$productOrderCtrl.translations['antibody.pdp.commerceCard.promotion.viewpromo']}}
{{$productOrderCtrl.translations['antibody.pdp.commerceCard.promotion.promocode']}}: {{promo.promoCode}} {{promo.promoTitle}} {{promo.promoDescription}}. {{$productOrderCtrl.translations['antibody.pdp.commerceCard.promotion.learnmore']}}
产品信息
11101-1-AP
种属反应
已发表种属
宿主/亚型
分类
类型
抗原
偶联物
形式
浓度
规格
纯化类型
保存液
内含物
保存条件
运输条件
产品详细信息
Immunogen sequence: MLEEDMEVA IKMVVVGNGA VGKSSMIQRY CKGIFTKDYK KTIGVDFLER QIQVNDEDVR LMLWDTAGQE EFDAITKAYY RGAQACVLVF STTDRESFEA VSSWREKVVA EVGDIPTVLV QNKIDLLDDS CIKNEEAEAL AKRLKLRFYR TSVKEDLNVN EVFKYLAEKY LQKLKQQIAE DPELTHSSSN KIGVFNTSGG SHSG (1-203 aa encoded by BC015021)
靶标信息
The Ras-related superfamily of guanine nucleotide binding proteins includes the R-Ras, Rap, Ral/Rec and Rho/Rab subfamilies. Increasing data suggests an important role for Rab proteins in either endocytosis or in biosynthetic protein transport. The process of transporting newly synthesized proteins from the endoplasmic reticulum to various stacks of the Golgi complex and to secretory vesicles involves the movement of carrier vesicles and requires Rab protein function. Rab proteins are also an integral part of endocytic pathways. Rab 23, also known as HSPC137, is a 237 amino acid member of the Rab family of proteins and localizes to the cytoplasmic side of the cell membrane. Rab 23 is believed to play a role in intracellular protein transportation and signal transduction mediated by small GTPases. Mutations in the gene encoding Rab 23 may result in Carpenter syndrome, also known as ACPS2 (acrocephalopolysyndactyly type 2), a condition characterized by obesity, cardiac defects, polysyndactyly and craniosynostosis.
仅用于科研。不用于诊断过程。未经明确授权不得转售。
生物信息学
蛋白别名: DKFZp781H0695; MGC8900; open brain 2; OTTHUMP00000040021; protein open brain; RAB 23; RAB family small GTP binding protein RAB 23; rab-15; Ras-related protein Rab-23; RP3-496N17.3; unnamed protein product
基因别名: AW545388; HSPC137; opb; opb2; RAB23
UniProt ID: (Human) Q9ULC3
Entrez Gene ID: (Human) 51715, (Mouse) 19335, (Rat) 367242